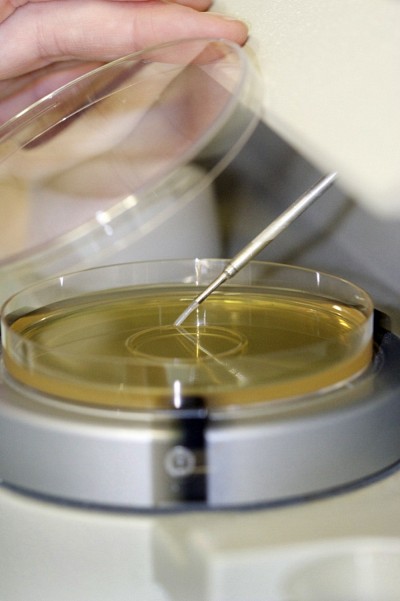
Val&eacute;rie a particip&eacute; activement &agrave; un projet de recherche et d&eacute;veloppement qui avait pour principal objectif d&rsquo;optimiser la stabilit&eacute; des ferments lactiques lyophilis&eacute;s.

Un stage inoubliable chez Lallemand en France
Microbiologiste sans frontière

Photo : Stéphanie Jaxel
Valérie Guénard-Lampron a donné tout son sens à l’expression populaire voulant que les voyages forment la jeunesse. Bien plus qu’une simple virée touristique, son séjour en France, plus particulièrement dans la ville de Toulouse, lui a en effet permis d’en apprendre un peu plus sur son futur métier de microbiologiste. Un métier qui la passionne maintenant plus que jamais!
Embauchée comme stagiaire par la division bactéries et procédés de la multinationale canadienne Lallemand, l’étudiante de troisième année au baccalauréat en microbiologie de l’Université de Sherbrooke a participé activement à un projet de recherche et développement qui avait pour principal objectif d’optimiser la stabilité des ferments lactiques lyophilisés.
La fermentation lactique est utilisée dans la fabrication de nombreux produits fermentés tels que les produits laitiers essentiellement (yaourts, fromages etc.), mais aussi de certains légumes (choucroute, olives, cornichons), de alcool (vin, cidre, bière), de charcuteries (jambon, saucissons), pains au levain etc. La fermentation modifie les textures et les saveurs des aliments d’origine et en améliore la conservation.
Dans un petit laboratoire d’une trentaine d’employés, elle a ainsi pu procéder à des tests lui permettant de trouver les meilleurs paramètres de fabrication et de conservation de bactéries lactiques à l’échelle industrielle. Elle a travaillé chez nos cousins entre août 2012 et avril 2013, ce qui représente deux stages successifs de quatre mois dans son cheminement universitaire de type coopératif (alternance études et stages).
Recherches stimulantes
«Plusieurs facteurs ont une influence directe sur la viabilité des bactéries tels la température, l'humidité, le pH, la présence d'oxygène, la résistance de la souche bactérienne aux différents chocs reliés au procédé de fabrication, vulgarise l’étudiante de 23 ans. Il fallait étudier tous les paramètres de la fermentation, de la concentration, de la cryoprotection, de la congélation et de la lyophilisation afin d’utiliser les meilleures conditions possibles pour une souche bactérienne en particulier.
«J’ai effectué plusieurs tests avec les bactéries produites dans deux usines de Lallemand, soit celle de Milwaukee aux États-Unis et celle de Saint-Simon en France», enchaîne-t-elle avec un enthousiasme contagieux. « Puisque j’ai été là-bas durant huit mois, j’ai eu la chance de voir certains résultats. C’était vraiment super! »
Employée à part entière
Valérie était considérée comme une employée à part entière au sein de l’équipe de son centre de recherche. Pas question de ne confier que des tâches de deuxième ordre à la stagiaire originaire de Saint-Charles-de-Drummond. Il s’agissait de son troisième séjour en entreprise après ceux au Bilariumde la Faculté de médecine et des sciences de la santé de l’Université de Sherbrooke (laboratoire du département de physiologie et biophysique) et au Centre de recherche et de développement sur les aliments d’Agriculture et AgroAlimentaire Canada (CRDA) à Saint-Hyacinthe.
Au Bilarium, la future microbiologiste a réalisé une étude sur la relaxation des muscles lisses tels que les muscles utérins et les bronches.
«Je devais recruter des patients afin d’obtenir leur autorisation pour récupérer un bout de tissu pulmonaire qui leur serait prélevé lors d’une opération prévue pour enlever une tumeur. Évidemment, il n’était pas question d’un prélèvement seulement pour la recherche, mais comme le chirurgien doit toujours retirer un peu plus pour être certain d’avoir retiré complètement la tumeur, il y a souvent quelques bouts de tissus encore sains. La même démarche étaient aussi utilisée pour obtenir des tissus utérins des femmes enceintes qui allaient avoir une césarienne», raconte celle qui a ainsi étudié l’impact de plusieurs molécules sur la relaxation des muscles lisses.
Au CRDA, le projet de recherche de Valérie portait sur la viabilité de fromages probiotiques de type cheddar digérés à l’aide d’un système de digestion in vitro.
«Cette étude pourrait mener à des applications industrielles ultérieures d’ajout de probiotiques dans un caillé de type cheddar donnant ainsi la possibilité aux transformateurs laitiers canadiens de développer de nouveaux produits ayant des propriétés santé», explique-t-elle.
Malgré son jeune âge, l’étudiante de l’Université de Sherbrooke a su se démarquer durant ses trois stages en milieu professionnel.
«Au-delà de sa rigueur et de son autonomie incontestées, qualités particulièrement appréciées chez les « débutants », Valérie m’a particulièrement marqué par sa motivation, son implication dans la vie du laboratoire, sa joie de vivre et sa soif de voyages», explique sa superviseure de stage, Stéphanie Jaxel.
«Travailler avec des cellules vivantes n’est jamais de tout repos et elle s’est toujours pliée à leurs contraintes, matinales ou vespérales, car toujours curieuse du résultat qu’elles vont produire. Très sociable mais aussi très responsable, Valérie a su parfaitement s’intégrer au laboratoire, aux personnes qui y travaillent mais aussi tout en se souciant d’y maintenir voire d’améliorer les conditions de travail», ajoute la chef de projets R&D, volet procédés bactéries.
Des voyages, des voyages et encore des voyages

En plus d’approfondir ses connaissances en biologie, Valérie a profité de son stage chez Lallemand pour voir du pays, beaucoup de pays. Celle qui terminera son baccalauréat au mois de décembre a en effet eu la chance d’aller visiter plusieurs endroits en Europe dont les incontournables Paris, Monaco, Nice, Bordeaux, Rome et Londres. Elle a même mis les pieds au Maroc durant un long congé!
«Au début, je n’allais pas très loin, mais après un certain temps, j’ai réalisé que je pouvais voir beaucoup de choses durant les fins de semaines. Les billets d’avions ne sont vraiment pas dispendieux en France alors j’en ai profité pour visiter, raconte-t-elle avec les yeux encore brillants. Puisque j’étais seule dans le temps des Fêtes, j’ai décidé d’aller visiter Rome en Italie. C’était vraiment extraordinaire.»
Tisser des liens
Les visites des plus belles régions de l’Europe resteront gravées à jamais dans la mémoire de l’étudiante sherbrookoise. Mais au-delà des contrées explorées, elle gardera dans son baluchon tous les liens humains qu’elle a tissés durant son stage.
«Ça n’a pas été facile de quitter, raconte-t-elle la voix nouée. Je me suis liée d’amitié avec plusieurs personnes là-bas et ce n’est pas dit que je n’y retournerai pas un jour.
«J’ai aussi accumulé beaucoup de contacts dans l’entreprise qui pourront me servir dans le futur. Et bien sûr, un stage de huit mois à Toulouse, ça paraît bien sur un curriculum vitae!» termine l’étudiante.
«Cette expérience avec Valérie m’a totalement convaincue de travailler à nouveau avec des étudiants de l’Université de Sherbrooke. Si l’on peut parfois avoir des a priori quant au recrutement d’étudiants étrangers, Valérie est la preuve vivante que réaliser un bon stage et découvrir les terres alentours est parfaitement possible», conclut quant à elle Stéphanie Jaxel.
*Cet article a été publié dans le journal In Vivo de l'Association des biologistes du Québec.